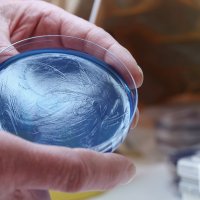
Bildet viser en petriskål med Pseudomonas aeruginosa.

– Vi lurte på om vi hadde sviktet på noe som gjorde at tre pasienter mistet livet

Men deres årvåkenhet forhindret at enda flere ble smittet.
I november døde tre pasienter på intensivavdelingen på Universitetssykehuset i Nord-Norge. Alle tre hadde korona, men de ble raskt veldig dårlige og utviklet septisk sjokk. I blodet deres fant man bakterien Pseudomonas aeruginosa.
Det er ikke noe uvanlig funn ved infeksjoner i sykehus. Men de alvorlige forløpene, så tett på hverandre i tid, fikk overlege Gro Grimnes til å stusse.
Kunne de tre pasientene være smittet med en bakterie av samme stamme? Og kunne det være snakk om et utbrudd?
Grimnes slo alarm på sykehuset.
– Veldig ubehagelig
Allerede samme uke ble det gjort en hurtigsekvensering, som viste at bakteriene hos de tre pasientene var like genetisk. Og at det var snakk om en stamme som ikke var beskrevet tidligere.
Da var etterforskningen allerede i gang.
Pårørende var varslet, avdeling for smittevern var koplet inn, smittevernkontakt Rita Pausen var i gang med å forsterke rengjøringsprosedyrer.
Intensiv- og fagutviklingssykepleierne Jannike Esaiassen og Inga Akeren fingransket de tre pasientene for å se om de kunne finne noe avvikende. Var det svikt i rutiner? Spesielle undersøkelser som var gjort? Noe felles hos disse tre, som kunne forklare at akkurat de ble smittet?
– Det var veldig ubehagelig, sier Inga Akeren.
– Vi spurte oss: Har vi sviktet på et eller annet punkt som gjorde at tre pasienter mistet livet?
Rita Paulsen, som har vært avdelingens smittevernkontakt i mange år, kjente det på kroppen.
– Jeg hadde generelt høyere puls, veldig lenge, sier hun.
– Det gikk gjennom hodet hele tiden: Har jeg fått informert om prosedyrer og rutiner til alle? Til faste, til vikarer, til assistenter?

Tilfeller også utenfor UNN
Dette var en tøff tid for UNN av flere grunner. Aldri hadde det vært så mange alvorlig syke koronapasienter her. Intensivkohorten var trang, arbeidsforholdene ikke de beste.
– Alle scenarioer gikk gjennom hodet, forteller Rita Paulsen.
– Mange ansatte gikk også og bekymret seg for om de var bærere av bakterien, legger Inga Akeren til.
– Og at det var vi som kunne ha smittet pasientene.
Sammen med Esaiassen gikk de gjennom de elektroniske kurvene. De avslørte at de tre pasientene aldri hadde ligget på samme rom. Altså var ikke smitten gått rett fra én seng til en annen.
Så ble det i slutten av desember meldt om tilfeller som ikke var på UNN. Flere sykehus i Helse Nord oppdaget bakterien hos sine pasienter. Med andre ord: Dette var ikke et lokalt utbrudd. Men kunne det være et regionalt utbrudd som bare rammet Nord-Norge?
Et landsdekkende utbrudd
Rita Paulsen ramser opp noen av spørsmålene de stilte seg:
– Hadde kanskje alle pasientene som var blitt smittet, vært innom UNN? Kunne de ha blitt smittet under transport? Eller kunne det være noen produkter som bare var i bruk i Helse Nord?
Så ble det avdekket at utbruddet hadde pågått siden oktober. Og at den antatt første pasienten med smitte ikke hadde noen forbindelser til UNN.
– Det var ikke ok at andre sykehus også hadde bakterien, men på en måte var det en slags lettelse, sier Rita Paulsen.
Samtidig tenkte hun: Hva er det vi gjør som påfører pasienter infeksjon?
– Mysteriet ble på en måte enda større, sier Inga Akeren.
Funn i kluter
Nå var den eksakte genetiske koden til den spesielle bakteriestammen kjent, og den ble sendt til sykehuslaboratorier over hele landet.
I mars ble det gjort funn i en spesiell type engangskluter som var mye brukt i blant annet intensivavdelinger.
At bakterien var i nettopp disse, overrasket ikke sykepleierne på UNN.
– De hadde vært høyt oppe på listen over mistenkte, sier Jannike Esaiassen.
– Vi vet at Pseudomonas aeruginosa trives i fuktige miljøer, som i prefuktet utstyr.
Stilte tusen spørsmål
Smittevernsykepleier Tina Bogetvedt jobbet tett med avdelingen under etterforskningen.
– Jeg stilte tusen spørsmål, sier hun.
Sammen undersøkte de håndvasker, spritdispensere, renhold, engangsutstyr og flergangsutstyr.
– Vi gransket absolutt alt, sier hun.
Men de fant ikke spor av bakterien.
– I det store og hele så var det betryggende, sier Bogetvedt.
– De har så gode rutiner.

Blir minnet på sårbarheten
Men for de tre som jobber på intensiv, har utbruddet vært en påminner om hvor sårbare pasientene deres er.
– Det er ubehagelig at noe så hverdagslig som en vaskeklut kan få store konsekvenser, sier Inga Akeren.
– Vi blir minnet på hvor utrolig disponert pasientene er for infeksjoner.
Underveis i etterforskningen var det ikke bare klutene som var under mistanke.
– Men også fuktere til respiratorer og utstyr til bronkoskopi. Vi lurte på om glyserolen vi brukte som glidemiddel på bronkoskopet, kunne være kilden og har endret prosedyre slik at vi nå bruker et sterilt glidemiddel.
En erfaring de tar med seg videre, er at rutiner aldri kan bli gode nok. Selv om smitten i dette tilfellet kom utenfra.
– Vi er glade for at vi har funnet årsaken og at rutinene våre er gode, sier Rita Paulsen.
– Men det hjelper ikke de stakkars menneskene som døde. At de ble påført smitte inne i sykehuset er bare forferdelig trist.
Tre tilfeller var et utbrudd
Om ikke klinikerne på UNN hadde reagert, kunne utbruddet gått under radaren en god stund. Ett og ett tilfelle her og der ville ikke nødvendigvis blitt satt i forbindelse med hverandre.
Da utbruddet ble erkjent, omfattet det tre pasienter på ett sykehus. Nå omfatter det 314 pasienter på 37 sykehus.
Infeksjonsmedisiner Gro Grimnes, som var den som først så sammenhengen, trekker frem dette:
– Når vi tenker på smitteutbrudd, tenker vi lett at det må være kjempestort. Men det trenger ikke være det.
Folkehelseinstituttet definerer utbrudd som «flere tilfeller enn forventet av en bestemt sykdom innenfor et område i et gitt tidsrom».
– Tre tilfeller er ikke veldig mange, påpeker Grimnes.
– Men det viste seg å være toppen av isfjellet.

0 Kommentarer